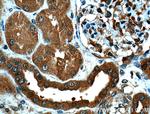
PSMD13 Antibody in Immunohistochemistry (Paraffin) (IHC (P))

Search
Proteintech
PSMD13 Polyclonal Antibody
{{$productOrderCtrl.translations['antibody.pdp.commerceCard.promotion.promotions']}}
{{$productOrderCtrl.translations['antibody.pdp.commerceCard.promotion.viewpromo']}}
{{$productOrderCtrl.translations['antibody.pdp.commerceCard.promotion.promocode']}}: {{promo.promoCode}} {{promo.promoTitle}} {{promo.promoDescription}}. {{$productOrderCtrl.translations['antibody.pdp.commerceCard.promotion.learnmore']}}
产品信息
15261-1-AP
种属反应
已发表种属
宿主/亚型
分类
类型
抗原
偶联物
形式
浓度
规格
纯化类型
保存液
内含物
保存条件
运输条件
产品详细信息
Immunogen sequence: MKDVPGFLQ QSQSSGPGQP AVWHRLEELY TKKLWHQLTL QVLDFVQDPC FAQGDGLIKL YENFISEFEH RVNPLSLVEI ILHVVRQMTD PNVALTFLEK TREKVKSSDE AVILCKTAIG ALKLNIGDLQ VTKETIEDVE EMLNNLPGVT SVHSRFYDLS SKYYQTIGNH ASYYKDALRF LGCVDIKDLP VSEQQERAFT LGLAGLLGEG VFNFGELLMH PVLESLRNTD RQWLIDTLYA FNSGNVERFQ TLKTAWGQQP DLAANEAQLL RKIQLLCLME MTFTRPANHR QLTFEEIAKS AKITVNEVEL LVMKALSVGL VKGSIDEVDK RVHMTWVQPR VLDLQQIKGM KDRLEFWCTD VKSMEMLVEH QAHDILT (1-376 aa encoded by BC001100)
靶标信息
Acts as a regulatory subunit of the 26S proteasome which is involved in the ATP-dependent degradation of ubiquitinated proteins.
仅用于科研。不用于诊断过程。未经明确授权不得转售。
生物信息学
蛋白别名: 26S proteasome non-ATPase regulatory subunit 13; 26S proteasome regulatory subunit p40.5; 26S proteasome regulatory subunit RPN9; 26S proteasome regulatory subunit S11; 26S proteasome subunit p40.5; proteasome (prosome, macropain) 26S subunit, non-ATPase, 13; unnamed protein product
基因别名: HSPC027; p40.5; PSMD13; Rpn9; S11
UniProt ID: (Human) Q9UNM6
Entrez Gene ID: (Human) 5719